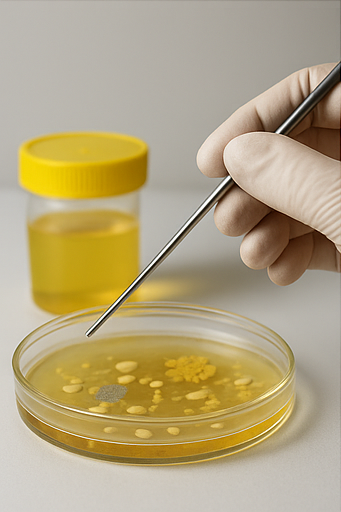

목차
소변 냄새, 그냥 넘기지 마세요
화장실에서 소변을 볼 때, 평소와 다른 냄새가 난다면 그냥 넘기지 마세요. 소변의 냄새는 우리 몸의 건강 상태를 알려주는 중요한 신호일 수 있어요. 특정 냄새가 나타날 때 어떤 건강 문제를 의심해야 하는지 알아보면 도움이 될 거예요.
소변 냄새로 의심할 수 있는 건강 상태
암모니아 냄새
소변에서 강한 암모니아 냄새가 난다면, 수분 섭취가 부족하거나 소변이 농축되어 있을 수 있어요. 물을 충분히 마시지 않으면 소변이 진해지고 냄새도 강해질 수 있으니, 수분 섭취를 늘려보세요.



달콤한 냄새
소변에서 달콤한 냄새가 난다면, 혈당 수치가 높아졌을 가능성이 있어요. 이런 경우에는 당뇨병을 의심해볼 수 있으니, 병원에서 검사를 받아보는 것이 좋아요.
썩은 냄새
소변에서 썩은 냄새가 난다면, 요로 감염이나 방광염 등의 질환을 의심해볼 수 있어요. 이런 경우에는 소변 색깔이 탁해지거나 통증이 동반될 수 있으니, 병원에서 진료를 받아보세요.



약물 냄새
특정 약물을 복용 중이라면, 소변에서 그 약물의 냄새가 날 수 있어요. 예를 들어, 비타민 B 복합체를 복용하면 소변에서 특유의 냄새가 날 수 있어요.
음식 냄새
특정 음식을 섭취한 후에는 소변에서 그 음식의 냄새가 날 수 있어요. 예를 들어, 아스파라거스를 먹은 후에는 소변에서 특유의 냄새가 날 수 있어요.



소변 냄새를 체크하는 방법
소변을 볼 때 잠시 멈춰서 냄새를 확인해보세요. 특히 아침 첫 소변은 몸 상태를 잘 보여주니까 주의 깊게 살펴보는 게 좋아요. 냄새가 평소와 다르거나 이상하다고 느껴지면, 그날의 수분 섭취량이나 먹은 음식, 복용 중인 약물을 생각해보세요. 그리고 이상이 계속되면 병원에 가서 검사를 받아보는 게 안전해요.
소변 검사, 건강을 알려주는 창문
소변 검사는 우리 몸의 건강 상태를 파악하는 데 중요한 역할을 해요. 간단한 검사지만, 다양한 질병을 조기에 발견할 수 있는 유용한 방법이랍니다.
소변 검사의 종류와 그 의미
1. 요시험지봉 검사
얇은 플라스틱 시험봉을 소변에 담가 색 변화로 여러 항목을 확인하는 검사예요. pH, 단백질, 당, 케톤, 혈뇨, 빌리루빈 등을 간편하게 측정할 수 있어요.
2. 요침사 검사
소변을 원심분리한 후 현미경으로 관찰하여 적혈구, 백혈구, 세균 등을 확인하는 검사예요. 요로 감염이나 신장 질환 등을 진단하는 데 사용돼요.
3. 24시간 소변 검사
하루 동안의 소변을 모두 모아 특정 물질의 배출량을 측정하는 검사예요. 호르몬, 단백질, 전해질 등의 이상을 확인할 수 있어요.
4. 소변 세균배양 검사
요로 감염이 의심될 때 소변에서 세균을 배양하여 어떤 균이 있는지 확인하는 검사예요. 적절한 항생제를 선택하는 데 도움이 돼요.

소변 검사로 알 수 있는 주요 질병
1. 요로 감염
소변에서 백혈구, 아질산염, 세균 등이 발견되면 요로 감염을 의심할 수 있어요. 배뇨 시 통증이나 잦은 소변 등의 증상이 동반될 수 있어요.
2. 당뇨병
소변에서 당이나 케톤이 검출되면 당뇨병을 의심할 수 있어요. 특히 케톤은 당뇨병이 조절되지 않을 때 나타날 수 있어요.
3. 신장 질환
소변에서 단백질이나 혈뇨가 발견되면 신장 질환을 의심할 수 있어요. 신장의 기능이 저하되면 이러한 물질들이 소변으로 배출될 수 있어요.
4. 간 질환
소변에서 빌리루빈이나 유로빌리노젠이 검출되면 간 질환을 의심할 수 있어요. 간의 기능이 저하되면 이러한 물질들이 소변으로 배출될 수 있어요.
5. 탈수
소변의 비중이 높아지거나 색이 진해지면 탈수를 의심할 수 있어요. 충분한 수분 섭취가 필요해요.
소변 검사, 어떻게 준비할까요?
- 아침 첫 소변 사용하기: 가장 농축된 상태로 정확한 결과를 얻을 수 있어요.
- 중간뇨 채취하기: 처음과 끝 부분은 버리고 중간 부분을 채취하면 오염을 줄일 수 있어요.
- 격렬한 운동 피하기: 운동 후에는 소변에 단백질이나 혈뇨가 일시적으로 나타날 수 있어요.
- 생리 중 검사 피하기: 여성의 경우 생리 중에는 결과에 영향을 줄 수 있으니 피하는 것이 좋아요.
'건강 > 당뇨관련' 카테고리의 다른 글
| 꿀과 당뇨병 알아보기 (0) | 2025.08.17 |
|---|---|
| 식후 2시간 혈당 정상수치 (0) | 2025.08.16 |
| 당뇨병 초기증상 (0) | 2025.06.06 |
| 소변 색깔이 갈색이라면? (0) | 2025.05.27 |
| 건강한 소변 습관 기르기 (0) | 2025.05.27 |